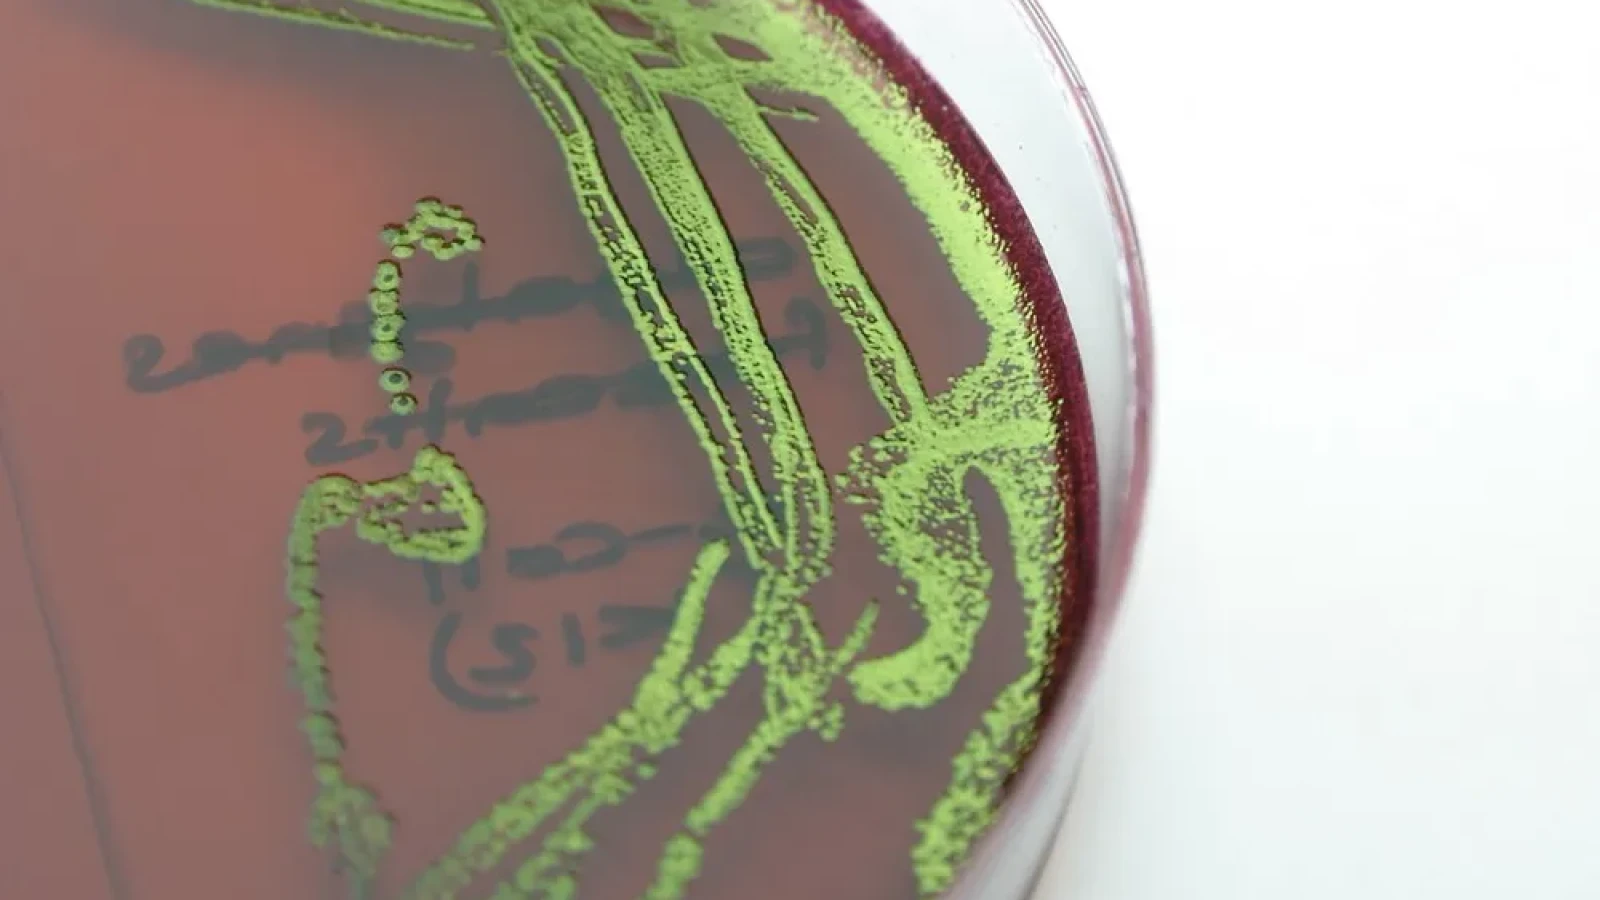
Article thumbnail

Cu prilejul Zilei Mondiale a Sindromului Hemolitic Uremic Atipic (SHUa), Societatea Română de Nefrologie (SRN) face un apel ferm la diagnostic timpuriu și acțiune coordonată în gestionarea acestei boli rare, severe și amenințătoare de viață. SRN subliniază necesitatea creșterii nivelului de conștientizare atât în rândul profesioniștilor din sănătate, cât și în populația generală, atrăgând atenția că fiecare oră câștigată până la stabilirea diagnosticului poate însemna vieți salvate și complicații evitate.
Despre sindromul hemolitic uremic atipic și importanța diagnosticului timpuriu
Microangiopatiile trombotice (TMA) sunt boli rare și grave în care se formează cheaguri de sânge în vasele foarte mici, putând afecta organe vitale precum rinichii, creierul sau inima, punând viața în pericol. O cauză importantă o reprezintă dereglarea unei componente a sistemului imunitar, numită sistemul complement. În mod normal, sistemul complement ajută organismul să lupte împotriva infecțiilor; când se dereglează, poate declanșa o reacție necontrolată în lanț, ducând la inflamație și distrugerea celulelor sănătoase, inclusiv a celulelor care căptușesc vasele de sânge. Semnele și simptomele posibile în TMA includ tensiune arterială crescută, oboseală, respirație grea, confuzie, cheaguri de sânge, anemie (lipsă de globule roșii), număr mic de trombocite și semne de afectare a rinichilor, creierului sau inimii.
Sindromul hemolitic uremic atipic este un tip de TMA cauzat de dereglarea sistemului complement. Poate apărea pe fond genetic sau declanșat de alti factori (de exemplu, infecții, sarcină, patologii oncologice). Debutul este adesea brusc, cu evoluție severă și risc major de afectare renală acută, complicații neurologice și cardiace si chiar deces.
Boala poate deveni cronică și poate recidiva. Deoarece nu există un test unic care să confirme sindromul hemolitic uremic atipic, diagnosticul este eminamente clinic, iar triada (anemie hemolitică, trombocitopenie, disfuncție renală) este înalt sugestivă; Cu cât boala este identificată și tratată mai repede, cu atât cresc șansele de protejare a organelor și de evitare a complicațiilor amenințătoare de viață. Recunoașterea timpurie și inițierea rapidă a tratamentului sunt esențiale pentru prognosticul pacientului.
„Recunoașterea rapidă a sindromului hemolitic uremic atipic face adesea diferența între salvarea vieții și recuperarea funcției renale versus pierderea ireversibilă a funcției rinichilor și deces. În fața triadei clinico-biologice sugestive (anemie hemolitică, trombocitopenie, afectare renală), este esențial ca pacientul să fie evaluat urgent de un medic nefrolog (specialist în boli de rinichi). Cu cât intervenția este mai rapidă, cu atât cresc șansele de recuperare și de evitare a complicațiilor severe,” a declarat Prof. Dr. Gener Ismail, Președinte în exercițiu, Societatea Română de Nefrologie.
„Rezultatele clinice depind de acțiunea coordonată eficientă: rute clinice clare, acces rapid la testări relevante și colaborare strânsă între nefrologie, hematologie, medicina de urgență, ATI și pediatrie. Timpii până la diagnostic si tratament trebuie reduși semnificativ pentru a crește șansele de recuperare ale pacienților,” a adăugat Prof.Dr. Adrian Covic, Președinte ales, Societatea Română de Nefrologie.
„Creșterea nivelului de conștientizare în rândul profesioniștilor din sănătate și informarea populației privind semnele de alarmă — tensiune mare, oboseală marcată, dificultăți de respirație, confuzie, anemie, trombocite scăzute, semne de afectare renală — conduc la prezentări mai timpurii și la rezultate clinice mai bune,” a subliniat Prof.Dr. Ina Kacso, fost Președinte, Societatea Română de Nefrologie.
Apel la acțiune: conștientizare și educație continuă
Profesioniștii din sănătate sunt încurajați să includă sindromul hemolitic uremic atipic în diagnosticul diferențial la pacienții cu anemie hemolitică, trombocitopenie și afectare renală acută și să inițieze prompt consult nefrologic. Unitățile sanitare sunt invitate să adopte protocoale locale și regionale pentru rute rapide de diagnostic și tratament în TMA, respectiv Sindrom Hemolitic Uremic atipic. Populația generală este încurajată să se adreseze medicului în fața simptomelor sugestive și a istoricului familial relevant; recunoașterea timpurie poate salva funcția renală și poate preveni complicații severe, amenințătoare de viață.

Comentează